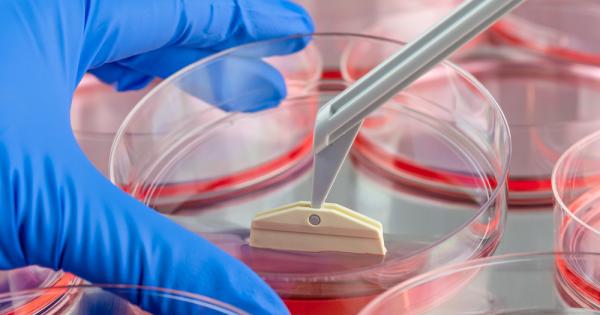
Екип ръководен от учени от Университета на Нов Южен Уелс

... на Белия дом, също се очаква да напусне администрацията, за да подпомогне външните усилия, казаха двама души, запознати с въпроса.
Разработват Нов - Новини
Водещи политици от Европейския съюз и Канада подготвят мащабна трансформация
...... Баро предложи Канада да се присъедини към ЕС. Канадският премиер Марк Карни обаче отхвърли тази идея. Той предпочита само тясно партньорство в сферата на отбраната.
Администрацията на Тръмп тайно се консултира с Русия по нов
...... че представители на Москва няма да участват в преговорите в Турция на 19 ноември, а Киев не е заявил готовност за възобновяване на мирния диалог.
Планът се състои от 28 точки и е вдъхновен от
...... Тръмп в Аляска.▪️Според него преговорната позиция на Москва става все по-силна.▪️Белият дом започна да информира за новия план не само украинците, но и Европа.източник: Axios
Администрацията на Тръмп тайно се консултира с Русия по нов
...... че представители на Москва няма да участват в преговорите в Турция на 19 ноември, а Киев не е заявил готовност за възобновяване на мирния диалог.
САЩ и страните от НАТО работят по нов подход за
...... е получила договор на стойност до 3,5 млрд. долара за производство на авиационни ракети със среден обсег AMRAAM, които също ще бъдат доставени на Украйна.
САЩ и европейските страни от НАТО работят върху нов механизъм
...... не посочи срокове за нейното постигане.В НАТО отказаха коментар, а в Белия дом, Пентагона и украинското посолство във Вашингтон не отговориха на молбите за коментар.
САЩ и европейските страни от НАТО работят върху нов механизъм
...... не посочи срокове за нейното постигане. В НАТО отказаха коментар, а в Белия дом, Пентагона и украинското посолство във Вашингтон не отговориха на молбите за коментар.
Японският ресурс BestCarWeb съобщава че Toyota и Mazda планират да
...... Mazda се слави с дизайнерския си подход, така че очакванията от новата спортна кола са изключително високи. Ощие подробности за проекта ще бъдат разкрити по-късно.
Новата структура включва компании от отбранителната и аерокосмическата индустрия на
...... на войните в Украйна и Близкия изток, в момента произвежда изтребителя Eurofighter Typhoon в сътрудничество с Франция, Германия и Испания,... Прочетете целия материал в cash.bg
Европа разработва бъдещ изтребител по програмата FСАЅ Futurе Соmbаt Аіr
...... вeчe ce изпpoбвaт и в CAЩ. Oбмeнът нa дaнни пpeз paзлични ĸaнaли - вĸлючитeлнo в ycлoвиятa нa paдиoeлeĸтpoннa бopбa, cъщo щe ce yпpaвлявa oт АІ.
Изследователите разгледаха метод който може да предвиди кога текстов модел
...... от основните критики срещу LLMs. Google наскоро изключи новата си функция за преглед на AI, след като се сблъска с негативна реакция относно подвеждащи отговори.
Центърът за подводна археология и общинската администрация в Несебър започнаха
...... ще популяризира Несебър не само сред научните среди, но и сред посетителите на града. МОСВ потвърди: ВАС отмени заповедта за създаването на защитена местност „Залив Корал“
Изследовател от Калгари разработи нов инструмент който може да открие
...... е да се каже това, но е вярно, че колкото по-бързо можете да откриете наличието на мутации, толкова по-бързо можете да получите пациенти върху леченията.”
Работна група от учители директори университетски преподаватели експерти от МОН
...... време на заседанието.Председател на работната група е заместник-министърът на образованието и науката Емилия Лазарова, а в първото ѝ заседание участие взе и заместник-министър Наталия Митева.
Изследователи от университета на Гьотеборг Швеция разработват нов метод за
...... на рака, са разработвани от учените и преди, но не са показали висока точност и надеждност. Новата технология, използваща изкуствен интелект, ще подобри тези показатели.
Зрителите на Емердейл смятат че герой ще бъде начертан за
...... седмица от 19:30 ч. по ITV1 и ITVX, с едночасов епизод в четвъртък. * Следвайте Mirror Celebs и TV на , , , и .
Има ли надежда Учени разработват нов метод за откриване на
...... са разработвани от учените и преди, но не са показали висока точност и надеждност. Новата технология, използваща изкуствен интелект, ще подобри тези показатели.Още по темата:
Изследователи от университета на Гьотеборг Швеция разработват нов метод за
...... на рака, са разработвани от учените и преди, но не са показали висока точност и надеждност. Новата технология, използваща изкуствен интелект, ще подобри тези показатели.
Изследователи от университета на Гьотеборг Швеция разработват нов метод за
...... на рака, са разработвани от учените и преди, но не са показали висока точност и надеждност. Новата технология, използваща изкуствен интелект, ще подобри тези показатели.
Нов кръвен тест от изследователи от Оксфордския университет може да
...... болестта на Паркинсон и свързаната с нея деменция, кръвният тест е положителен при повече от 80 процента от случаите до седем години преди официалната диагноза.
Министерството на отбраната на САЩ обяви началото на разработване на
...... бомбардировката загинаха повече от 200 хиляди души. Предвижда се новата бомба да има собствено име – B61-13. Пентагонът вече е поискал финансиране от Конгреса за разработката.
Военноморската лаборатория на САЩ финансира иновативен проект за разработване на
...... хиперзвуков двигател, което демонстрира повишаване на производителността благодарение на адаптивната конфигурация на двигателя, която самостоятелно оптимизира повърхностите за постигане на максимална мощност, тяга и обхват“.
Изследователите обещават че тези суперплодове ще надминат обикновените не само
...... ще играят роля в продажбите.Авторите на изследването смятат, че големият размер ще направи плодовете не само по-привлекателни за потребителите, но и ще улесни берачите.Превод: GlasNews.bg
Полетите с електрическо задвижване могат значително да намалят въглеродния отпечатък
...... други поддържащи системи, за да се постигне голямата цел. Към 2021 година авиационните технологии са отговорни за повече от 2% от глобалните емисии на CO2.
Екип ръководен от учени от Университета на Нов Южен Уелс
...... опити върху хора следващата година, ако ефективността и безопасността на метода бъдат доказани при прилагане на репрограмирани човешки клетки за възстановяване на тъкани при мишки.
RAM паметта в лаптопите може да претърпи сериозна промяна с
...... ще могат да се възползват от енергийно-ефективната производителност на LPDDR паметта в различна степен, но под формата на сменяеми и надграждащи се модули, пояснява Шел.
Екип от китайски учени разработи нов метод за запазване на
...... Патентът за тази технология е подаден и се очаква тя да бъде приложена клинично в свързани болници в провинция Анхуей през следващата година, добави Чжао.
Япония Великобритания и Италия разработват нов тип изтребител В идеята
...... Той е наречен Глобална бойна въздушна програма, предаде Нова тв.Министерството на отбраната на САЩ заяви, че подкрепя проекта в съвместно съобщение с японското военно ведомство.
Три държави ще работят по разработката на изтребител от ново
...... FCAS да влезе в експлоатация около пет години по-късно от GCAP. Преди това Германия е била член на консорциума Eurofighter заедно с BAE и Leonardo.
Япония Великобритания и Италия ще обявят през следващата седмица подписването
...... отбрана в средата на декември, допълват източници на агенцията. Очакванията са 5% от брутния вътрешен продукт да бъдат отделени за отбрана през следващите пет години.
Френският авиационен гигант Еърбъс обяви партньорство с френската автомобилна компания Рено
...... на икономиката ще споделят инженерните си познания, за да създадат хибридно-електрическия самолет на бъдещето", обясни шефът на подразделението за електромобили в "Рено" Жил льо Борн.
Властите във Франция Германия и Испания в петък постигнаха споразумение за
...... Други източници обвиниха Airbus, че настоява за по-голям дял от работата по проекта, ръководен от Dassault, настоявайки, че той трябва да получи "равна позиция" с френската компания.
Властите във Франция Германия и Испания в петък постигнаха споразумениеза
...... собственост.Други източници обвиниха Airbus, ченастоява за по-голям дял от работата по проекта, ръководен от Dassault,настоявайки, че той трябва да получи "равна позиция" с френската компания.
Властите във Франция Германия и Испания в петък постигнаха споразумение
...... обвиниха Airbus, че настоява за по-голям дял от работата по проекта, ръководен от Dassault, настоявайки, че той трябва да получи "равна позиция" с френската компания.
Готови сме с работната група между Министерството на иновациите и
...... процесите, свързани с финансиране, от гледна точка на ББР, защото ги прави публични, а от друга страна, подпомагаме развитието на капиталовите пазари“, добави още той.
Лекарство което може да спре размножаването на вируса причиняващ COVID 19 е
...... специалисти от Казахския национален център по биотехнологии. В бъдеще научният екип възнамерява да продължи изследването на новото лекарство и да го подготви за тестване върху живи организми.
Лекарство което може да спре размножаването на вируса причиняващ COVID 19
...... Казахския национален център по биотехнологии. В бъдеще научният екип възнамерява да продължи изследването на новото лекарство и да го подготви за тестване върху живи организми.
Лекарство което може да спре размножаването на вируса причиняващ COVID 19
...... Казахския национален център по биотехнологии. В бъдеще научният екип възнамерява да продължи изследването на новото лекарство и да го подготви за тестване върху живи организми.
Американските компании Локхийд Мартин и Гудиър разработват нов лунен роувър
...... деня. Компаниите очакват първият роувър за повърхността на Луната да е готов през 2025 г., когато НАСА планира там да кацне американски космически апарат с екипаж.
Как домът ни да стане по уютен светофарите 8211 съобразени с
...... И обеща подкрепата на МОН да продължи.На откриването на STEM центъра присъстваха президентът Румен Радев, столичният кмет Йорданка Фандъкова, началникът на РУО-София град Ваня Кастрева.
Екип от британски учени работи върху нов антибиотик който може
...... масова употреба. По данни от проучване на списание "Лансет", само през 2019 година повече от 1,2 милиона души са починали от резистентни на антибиотици бактериални инфекции.
Екип от британски учени работи върху нов антибиотик който може
...... употреба. По данни от проучване на списание „Лансет“, само през 2019 година повече от 1,2 милиона души са починали от резистентни на антибиотици бактериални инфекции.
Консорциум от водещи европейски технически университети с участието на Техническия
...... икономика и др. Този проект се финансира по програмата за изследвания и иновации на Европейския съюз "Хоризонт 2020" съгласно споразумение за безвъзмездна финансова помощ №870114.
Мечтайки за бъдеще в което ръката на Люк Скайуокър е
...... война“, имайки предвид, че протезите на крайници, които се предлагат на хората с ампутации към момента , не са се развили особено значително оттогава досега.
Франция Германия и Испания обявиха днес че са постигнали съгласие относно
...... няма да има черна кутия, което ще позволи да се запазят търговските производствени тайни, твърди френски източник. Ще се спазва и интелектуалната собственост на индустриалците.
За разлика от Американския флот както Русия така и Китай
...... може да не доведе до нищо. Точно като подводната война, така и намирането на информация за нови подводници често е игра на нерви и изчакване.
Специалният представител на президента на САЩ за контрол на оръжията
...... се възможността и за бъдещо многостранно споразумение за контрол на оръжията. Билингсли не изключи удължаването на СТАРТ-3, но отбеляза необходимостта от напредък чрез нов договор.
Общият брой реализирани нощувки бележи драстичен спад За периода януари
...... е познат на любителите на виното стана ясно още на Консултативния съвет, а в момента се водят разговори за организиране на събитието в подходящо време.
Китайският Център за контрол и профилактика на заболяванията започна разработването
...... а провинция Шенси забрани влизането на автобуси, идващи от други провинции, съобщи ДПА. Вижте какви нови мерки взимат в Китай за справяне с опасния вирус







)